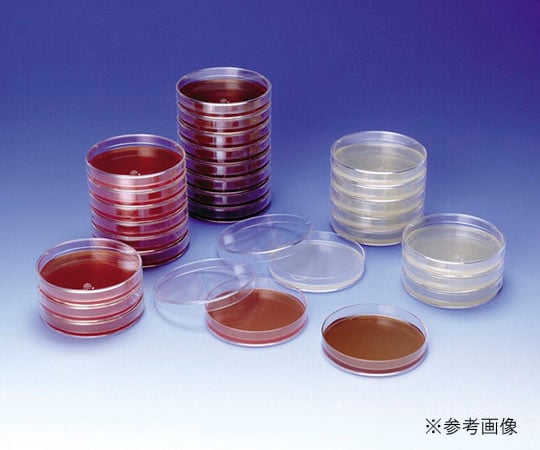
Raw medium Poremedia Potato Dextrose Agar 1 pack (10 sheets) 8-MR24 1 pack (10 sheets)

1
/
of
1
栄研化学
Raw medium Poremedia Potato Dextrose Agar 1 pack (10 sheets) 8-MR24 1 pack (10 sheets)
Raw medium Poremedia Potato Dextrose Agar 1 pack (10 sheets) 8-MR24 1 pack (10 sheets)
Regular price
¥990
Regular price
Sale price
¥990
Unit price
/
per
Shipping calculated at checkout.
Couldn't load pickup availability
Raw medium for fungal growth, isolation and counting
Contents: 10 sheets
Storage method: 2 to 10℃
View full details